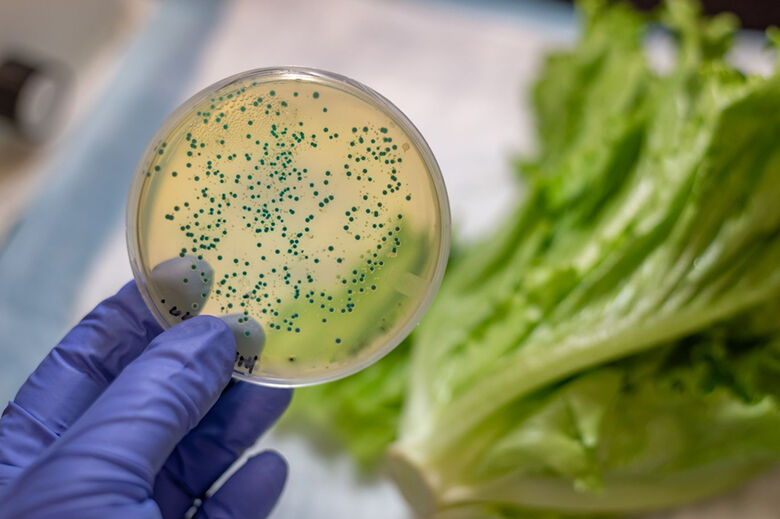
Águas e alimentos contaminados infectam 96 pessoas no Alto Tietê

O Alto Tietê registrou, ao longo de 2025, oito surtos de doenças de transmissão hídrica e alimentar (DTHA), que resultaram em 96 pessoas doentes, segundo dados do Núcleo de Informações Estratégicas em Saúde (Nies), da Secretaria de Estado da Saúde de São Paulo.
As ocorrências foram contabilizadas nos municípios de Mogi das Cruzes, Poá e Guararema. Mogi concentrou o maior número de registros, com cinco surtos e 72 doentes. Em Guararema, foram identificados dois surtos, com 20 pessoas afetadas, enquanto Poá registrou um surto, com quatro doentes.
De acordo com o levantamento, os surtos foram identificados em eventos, creches, restaurantes e padarias, locais que envolvem consumo coletivo de alimentos e água, ampliando o risco de transmissão.
As doenças de transmissão hídrica e alimentar são causadas, principalmente, pela ingestão de água ou alimentos contaminados por bactérias, vírus, parasitas ou toxinas. Os sintomas mais comuns incluem diarreia, febre, vômito, náuseas e dor abdominal, podendo surgir, em alguns casos, cefaléia, tontura, vertigem, distúrbios visuais, torpor e até paralisias, conforme o agente envolvido.
O Ministério da Saúde alerta que existem mais de 250 tipos de DTHA no mundo. É considerado surto de DTHA quando duas ou mais pessoas apresentam doença ou sinais e sintomas semelhantes após ingerirem alimentos e/ou água da mesma origem, normalmente em um mesmo local.
Prevenção
Ainda segundo o Ministério da Saúde, a prevenção, o controle e a redução dos riscos de surtos de doenças de transmissão hídrica e alimentar passam, principalmente, por investimentos públicos em saneamento básico, além da adoção de medidas individuais e coletivas de higiene e segurança alimentar.
Entre as recomendações estão a lavagem frequente das mãos com água limpa e sabão, especialmente antes de preparar ou consumir alimentos, após o uso do banheiro, após o manuseio de carnes cruas, contato com animais, uso de transporte público ou ao retornar da rua. O cuidado também deve ser redobrado antes e depois de amamentar e na troca de fraldas.
O Ministério orienta ainda o consumo de carnes bem cozidas ou assadas, água tratada e alimentos preparados e armazenados em condições adequadas de higiene. Alimentos prontos devem ser mantidos separados de produtos crus ou semi prontos, respeitando as temperaturas indicadas para conservação, tanto quentes quanto refrigerados. Preparações mantidas fora da temperatura segura devem ser consumidas em curto intervalo de tempo, evitando o risco de contaminação.
Outro ponto de atenção é a higienização correta de frutas, legumes e verduras, que deve incluir lavagem em água corrente e desinfecção com solução de hipoclorito de sódio antes do consumo.
Para famílias sem acesso à água tratada, a orientação é realizar o tratamento domiciliar da água, por meio de filtração seguida do uso de hipoclorito de sódio ou fervura por, no mínimo, cinco minutos. A recomendação é adicionar duas gotas de hipoclorito a 2,5% para cada litro de água e aguardar 30 minutos antes do consumo.
Entre as medidas complementares estão a busca por atendimento de saúde diante do surgimento de sintomas, a vacinação de crianças contra o rotavírus e o incentivo ao aleitamento materno, considerado um fator de proteção contra doenças infecciosas.

Águas e alimentos contaminados infectam 96 pessoas no Alto Tietê - (Foto: Divulgação)
Águas e alimentos contaminados infectam 96 pessoas no Alto Tietê - (Foto: Divulgação)




